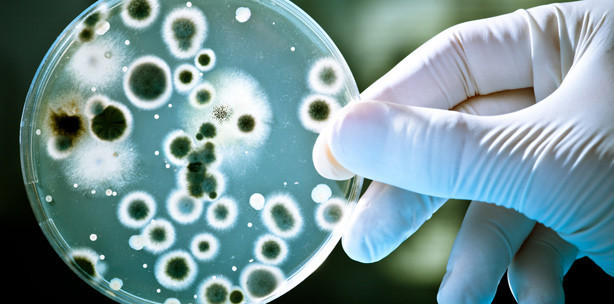
Durchfallerreger: Hysterie fehl am Platz

Branchenmeldungen 26.05.2011
Durchfallerreger: Hysterie fehl am Platz
Der Anstieg der vom EHEC-Bakterium ausgelösten Durchfallerkrankung in Deutschland -über 140 schwere Fälle und drei Todesopfer wurden binnen weniger Wochen gemeldet - erfährt in ganz Europa enorme Aufmerksamkeit. Während Deutschlands Verbraucherschutz-Ministerin Ilse Aigner die Ausbreitung als "besorgniserregend" einstuft, geben die österreichischen Behörden Entwarnung. "Bisher dokumentierte Fälle hängen nicht mit jenen in Deutschland zusammen. Es gibt daher keinen Grund zur Aufregung", betont Thomas Kvicala, Sprecher des Gesundheitsministers.
EHEC ist nicht Schweinegrippe
Zwar waren auch hierzulande einzelne Medien auf die deutsche Hysterie-Welle aufgesprungen wie etwa das Boulevardblatt "Heute", das mit "Erste Österreicherin tot" titelte. Der besagte Todesfall stammt jedoch noch vom März. Seitens des Ministeriums will man diesen Entwicklungen mit rascher, vollständiger und umfangreicher Aufklärung entgegentreten. "Niemand soll den Eindruck haben, dass etwas verheimlicht wird. Deshalb ist wichtig, dass alle weiteren Ergebnisse der Untersuchungen kommuniziert werden", so der Ministersprecher.
Dass sich EHEC zum nächsten Schreckgespenst nach der Schweinegrippe entwickeln wird, schließt Pamela Rendi-Wagner, Leiterin der BMG-Sektion für den öffentlichen Gesundheitsdienst, gegenüber pressetext definitiv aus. "Erstens geht es nicht um einen Virus, sondern um einen Darmkeim, zudem ist dieser bereits weltweit bekannt. In Österreich gibt es jährlich rund 60 bis 100 Erkrankungen, von denen im Schnitt eine tödlich verläuft. Ausbrüche gibt es immer wieder, in Deutschland derzeit allerdings in größerem Ausmaß als bisher."
Baldiger Rückgang zu erwarten
Laut jüngsten Informationen des Berliner Robert Koch-Instituts (RKI) http://www.rki.de , das an der Aufklärung der Krankheitsursache federführend ist, konnte noch immer kein konkretes Lebensmittel als Infektionsquelle identifiziert werden. Die allgemeinen Empfehlungen wie strikte Händehygiene bei Durchfall sowie der Arztbesuch bei blutigen Durchfällen zwecks EHEC-Nachweis seien jedoch in besonderem Maße gültig. Ähnlich wie zuletzt RKI-Leiter Reinhard Burger geht auch Rendi-Wagner von einem baldigen Abflauen der Fälle aus.
Ein Rückgang ist auch bereits bei der Aufmerksamkeit der Medien zu verzeichnen. Im Wiener Ministerium sank die Zahl der Anfragen zum Thema nun wieder deutlich, während das RKI auf Anfrage von pressetext noch von "anhaltend hohem Interesse seit Montag" berichtet.